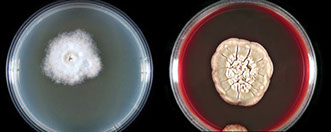
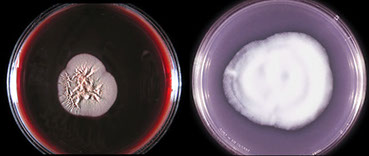
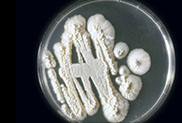

Mycology
Introduction
Actinomyces
Alternaria
Aspergillus sp
Blastomyces dermatitides
Blastomyces brazilensis
Candida sp
Coccidiodes immitis
Cryptococcus neoformans
Geotrichum sp
Histoplasma capsulatum
Nocardia
Phycomycoses
Pneumocystis carinii
Strongyloides stercoralis
Saprophytic Fungi
Systemic Mycoses
Superficial and Dermatophytic Mycoses
Subcutaneous Mycoses
Yeasts
Introduction



Macroconidia and Microconidia in Microsporum canis




Cryptococcus


Actinomyces
Bacteria that is considered a contaminant in the sputum
- non-pathogenic and can normally be found in the mouth and tonsils
Alternaria
Airborne fungus considered a contaminant
Aspergillus sp
Can be a contaminant or found as an infection within immunosuppressed pts
- acquired through inhalation
Thick, uniform septate hyphae with 45 degree angle branching
*** the "A" in aspergillus is like the 45 degree branch***
May see the conidiophore (fruiting head structure) when the surface is exposed to air
May cause squames to react, mimicking SCC
Aspergillus niger assoc c calcium oxalate crystals
Blastomyces brazilensis
South American form of this fungus
Candida sp
Opportunistic fungus that may be a contaminant or an infection within severely immunosuppressed pts
Can see pseudohyphae and buds
Coccidiodes immitis
aka Valley Fever, is found in the southwestern US
Appears as a large spherical capsule with endospores
- endospores may be within a giant cell or roaming freely in the background
Cryptococcus neoformans
Fungus found in feathers and bird droppings (pigeons), thus seen in ornithologists and orniphiles(?)
- may also cause meningitis (can see in CSF)
Affects primarily immunocompromised pts
Single or budding spheres with thick capsules (which can stain with mucicarmine from glycogen)
- budding portion may appear like a tear-drop shape
Birdseed agar selective and differential medium for C neoformans and C gatti
Geotrichum sp
Opportunistic fungus with 90 degree angle branching and septation
- has rectangular anthrospores which are non-budding structures
Nocardia
Filamentous bacteria present in the soil
- can mimic fungal hyphae
Phycomycoses
Mucor and rhizopus are within this group
Flat ribbon-like hyphae without septae
- 90 degree right angle branching
Pneumocystis carinii
Parasite whose incidence is increasing due to prevalence of AIDS
- can be fatal in both kids and adults
- cannot be cultured as it is a protozoa (thus increasing the value of cytology)
Amorphous eosinophilic mass in pap stained material with superimposed little circles within this mass that appear cup shaped to crescent and are non-budding
Pneumocystis jiroveci
"Crushed ping pong balls" that stains with Grocott stain; see intracystic bodies
Strongyloides stercoralis
Nematode that can be found in patients on steroid tx
- the larva of a filariform worm that migrates from the GI to the alveolar space through the blood
Mycology Lab Safety!!!!
- recommended that slide cultures not be performed on four classic causes of systemic mycoses
- Culturing filamentous fungi in the lab should be done in a separate room
- suitable biological safety cabinet (Class II BSC) must be used
- Yeast cultures can be handled on the normal work-bench area
- Gloves, masks, and gowns must be worn when working with mold cultures
- All contaminated material must be autoclaved before being discarded
● There are about 200,000 species of fungi
● Only about 100 consistently produce human mycoses
● Most species that infect humans are limited by nutritional requirements
● A few species can cause life-threatening illness
MYCOSES BASED ON BODY SITE
1. Superficial Mycoses
● Affect only the outermost layers of skin & hair
● Little or no pathology
2. Cutaneous Mycoses
● Involves destruction of the keratin of skin, hair, & nails; deeper body tissues are rarely invaded
● Primarily caused by the "Dermatophytes (Trichophyton, Microsporum, Epidermophyton) also Candida
3. Subcutaneous Mycoses
● Involve skin, muscle, and connective tissue immediately below the skin, usually traumatic implantation
● Deeper tissue involvement is rare
● Diseases include Chromoblastomycosis, Mycetoma, and Sporotrichosis
4. Systemic Mycoses
● Affects the deep tissues and organs of the body
● In disseminated forms of these diseases, subcutaneous and cutaneous areas may also be involved; usually acquired by inhalation
● Diseases include Blastomycosis, Coccidioidomycosis, Paracoccidioidomycosis, and Histoplasmosis
GENERAL CHARACTERISTICS
● Fungi can be easily differentiated into two basic types based on the macroscopic appearance of their colonies
● Molds produce cottony, woolly, fluffy, or powdery aerial growth above the culture medium
● Yeasts produce opaque, creamy, or pasty colonies
DISTINCTIONS BETWEEN FUNGI AND BACTERIA
FUNGI BACTERIA
Eucaryotic Prokaryotic
Mitochondria No Mitochondria
Nuclear Membrane No Nuclear Membrane
Endoplasmic Reticulum No Endoplasmic Reticulum
C.W. of Chitin / Cellulose No Chitin in C.W.
Sterols in CM No sterols in CM
CLASSIFICATION
● The true fungi are in the kingdom Myceteae
● In practice the class names are normally used
-- fungi classified based on sexual reproduction
Class Zygomycetes
● Hyphae lack regular septations (aeseptate)
● Sexual spores are called Zygospores
● Asexual Sporangiospores are formed by internal cleavage of a sac called a Sporangium
● None are considered frank pathogens for humans
● Can cause opportunistic diseases that are life-threatening
● Genera include Rhizopus, Mucor, and Absidia
Class Ascomycetes
● Form sexual spores within a sac-like structure, an Ascus
● Hyphae have regular septa or cross walls
● May grow as single cells
Class Basidiomycetes
● Sexual Basidiospores are borne externally on club-shaped cells called Basidia
● Asexual reproduction may occur by budding, by means of conidia, or by fragmentation
● Hyphae are usually septate
● Includes mushrooms and teleomorphs of Cryptococcus
Class Deuteromycetes
● Large group of fungi for which no sexual stage has been observed
● Fungi Imperfecti
● All fungi may have a perfect stage in nature
● The sexual stage for most fungi of medical importance has not been demonstrated
MICROSCOPIC MORPHOLOGY
Hyphae
● Long strands of cells which intertwine and form a mat called a Mycelium
● Aseptate Hyphae have no cross walls or septations, are wide and ribbon-like, 6-10μm in diameter
● Septate Hyphae have very evident septations and are thinner with a diameter of 3-4μm
● In culture, hyphae can also be divided into vegetative forms and aerial hyphae
● Nonreproductive vegetative hyphae include; Favic chandeliers, Nodular organs, Raquet hyphae, Spiral hyphae
Yeasts
● Yeasts consists of individual oval to round cells which frequently bud to form daughter cells
Dimorphism
● Most fungi exist only as molds or as yeasts
● Some fungi may exhibit two distinct phases (Dimorphism)
● Most dimorphism is temperature depent
● Thermally dimorphic fungi grow as molds at room temperature (25 C) and as yeasts at body temperature (37 C)
***HEAt = YEAst, COLD=MOLD***
● Conversion from one form to the other is one of the primary aids in identifying these fungi
● Most dimorphic fungi produce serious & often fatal systemic disease
REPRODUCTION
● Fungi exhibit numerous types of reproduction, both sexual and asexual
Asexual Reproduction
● Represented by nuclear and cytoplasmic division or mitosis
a) Conidia
● A conidium is an asexual spore borne freely as opposed to being produced in a sac
● Microconidia are generally very small and usually single-celled
● Macroconidia are larger and normally multi-celled
● Other specialized types of conidia include; Blastoconidia, Poroconidia, Phialoconidia, Annelloconidia, Chlamydoconidia, and Arthroconidia
b) Sporangiospores
● Asexual spores formed by internal cleavage of a sac called a sporangium
Sexual Reproduction
a) Ascospores, as in the Ascomycetes
b) Basidiospores, as in the Basidiomycetes
c) Zygospores, as in the Zygomycetes
COLONIAL MORPHOLOGY
Texture
● Include the terms; cottony, woolly, fluffy, velvety, suede-like, powdery, granular, downy, hair-like, floccose, etc.
Topography
● Include the terms; flat, heaped, folded, rugose, etc.
Color
● Colors vary from white, black, yellow, buff, cinnamon, tan, red, red-yellow, wine red, salmon pink, etc.
● Color on colony surface may be different from the color on the reverse of the colony
OBTAINING AND PROCESSING SPECIMENS
General Considerations
● Procedures as for bacterial isolation are generally followed
● Generally, specimens should not be frozen or allowed to dry, rather, they should be refrigerated or left at room temp.
Sources
● Specimens are normally taken from the site of infection and may include the following; Sputum, Bronchoscopy, CSF, Urine, Exudates, Prostatic secretions, Tissue biopsies, and Blood
● Hair, Skin, and Nails are submitted for isolation of the Dermatophytes
DIRECT EXAMINATION OF SPECIMENS
● Saline Wet Preparation (yeasts, hyphae, pseudohyphae, conidia, branching filaments, granules, spherules, etc.)
● Lactophenol Cotton Blue (stains the chitin of fungal cell walls)
● KOH Prep (dissolves the keratin of hair, skin, and nails)
● Gram Stain (fungi stain Gram positive - yeasts & pseudohyphae)
● Acid-Fast Stain (used to stain Nocardia spp.)
● India Ink Preparation (Cryptococcus neoformans in CSF)
● Other Stains (Calcofluor White, Gomori Methenamine Silver, H&E stain, Wright stain, etc,)
CULTURING THE SPECIMEN
Primary Fungal Media
● Sabouraud Dextrose Agar
● Sabouraud Dextrose Agar + Cyclohexamide + Chloramphenicol
● Brain Heart Infusion Agar + Blood
● BHI + Blood + Cyclohexamide + Chloramphenicol
Incubation
● Fungal cultures should be incubated at 25-30○C (or room temp.)
● Cultures should be incubated for 30 days before being discarded as negative
Examination of Cultures
● Tease Mount
● Slide Culture Method
Seromycology
● Skin tests are available for the Systemic Mycoses
● Some serological tests are available for detecting Ab in patients serum
● Exoantigen test is available for the Systemic Mycoses (specific identification of fungal antigens)
Yeast Identification
● Conventional biochemical tests are available for yeast identification.
● There are also a number of manual kits as well as yeast systems designed to be used with instrumentation. (API20C / RapID Yeast Plus System)
Saprophytic Fungi
● Saprophyte: any vegetative organism that lives of dead or decaying vegetation.
● Saprobic: living on decaying matter in the soil
PROPERTIES COMMON TO FUNGAL CONTAMINANTS
● Most are rapid growers (mature colonies within four or five days)
● Most are saprobic and become easily airborne
● The conidia of the saprophytes are normally inhaled
● The saprophytes are opportunistic pathogens
● Media w/o antibiotics must be used for isolation
ASEPTATE SAPROPHYTES
ABSIDIA SPP.
- aka Lichtheimia corymbifera
● Sporangiophores between rhizoids on stolon (internodal)
● Sporangia are normally pear-shaped
● May cause zygomycosis and mycotic keratitis
MUCOR SPP.
● Sporangiophores arise directly from mycelium (branched or single)
● Round sporangia, no rhizoids or stolons
- rapid growth, mature in 4 days
● May cause zygomycosis, otomycosis, and allergies
RHIZOPUS SPP.
● Unbranched sporangiophores arise opposite rhizoids
● Stolons connect rhizoids
● May cause zygomycosis and otomycosis
SEPTATE SAPROPHYTES
DEMATIACEOUS CONTAMINANTS
● Having structures that are brown to black due to a melanotic pigment in the cell walls
- hyaline contaminants - clear, transparent and colorless fungal elements
Alternaria spp.
● Chained poroconidia which contain horizontal & vertical septa and are club shaped with tapering ends, dark greenish to black-brown colonies
● May cause mycotic keratitis, skin infections, osteomyelitis, pulmonary disease, and nasal septum infection
Aureobasidium spp.
● Smooth yeast like colonies that become black and leathery with age
● Dark brown irregular 1-2 celled arthroconidia from which secondary blastoconidia may arise
● Two types of hyphae are observed
● May cause foot & leg lesions and allergies
- rarely causes phaeophyphomycosis and systemic infections
Cladosporium spp.
● Short chains of dark 1-4 celled blastoconidia borne from repeatedly forking shield cells
● Colonies are powdery or velvety, heaped and folded, and require seven days to mature
● May cause mycotic keratitis and allergies
Curvularia spp.
● Large 4-5 celled dark poroconidia
● Central cell of the conidium is enlarged resulting in a boomerang shape
● May cause mycotic keratitis, mycetoma, endocarditis, pulmonary infection, allergies, infection of the nasal septum
Bipolaris spp.
● Dark cylindrical 4-5 celled poroconidia usually borne in clusters
● Conidiophore has a "bent knee" angle
● May cause infection of the nasal mucosa, meningitis, allergies, peritonitis, and phaeohyphomycosis
Epicoccum spp.
● Thick clusters of short conidophores
● Terminal dark round conidia with unconstricted horizontal and vertical septa
● Conidia become rough walled with age
● Associated with allergies
Nigrospora spp.
● Short fat conidiophores
● Conidia are black, single, oval shaped, smooth walled
● May cause mycotic keratitis
HYALINE CONTAMINANTS
Acremonium spp.
● Colonies are wrinkled, membranous, later covered with loose aerial mycelium
● Unbranched tapering conidiophores
● Closely packed balls of elliptical shaped conidia
● May cause mycotic keratitis, mycetoma, lesions of hard palate, meningitis, arthritis, and systemic disease
Aspergillus spp.
● Characteristic foot cell supporting a large vesicle
● May cause diseases referred to as Aspergillosis
a) Aspergillus fumigatus
● Single row of flask shaped phialides on upper half of vesicle
● Smooth conidiophores
● Most common species of the genus, more invasive than other spp
b) Aspergillus flavus
● Double row of phialides cover entire vesicle
● echinulate conidiophores (rough, pitted, spiny)
c) Aspergillus niger
● Double row of phialides cover entire vesicle
● Smooth conidiophores
● Colonies eventually turn black
Chrysosporium spp.
● Short conidiophores poorly differentiated from mycelium
● Single round to club shaped conidia (rough or smooth) that can form directly on hyphae or at the end of simple short conidiophores
● Rarely reported as a pathogen
Fusarium spp.
● Microphioloconidia are one celled and occur in balls
● Macrophialoconidia are 2-5 celled, banana or cylindrical shaped with a distinctive foot cell at point of attachment
● F solaris is the MCC of mycotic keratitis
● May also cause skin lesions in burn patients, onychomycosis, otomycosis, varicose ulcers, mycetoma, osteomyelitis
Gliocladium spp.
● Masses of hyaline to green phialoconidia held together in a large ball by a gelatinous matrix
● Not known to be a human pathogen
Paecilomyces spp.
● Elongated phialides bearing chains of oval shaped conidia
● Conidia may be rough or smooth, pigmented or hyaline
● May cause penicillosis, endophthalmitis, endocarditis, skin lesions
Penicillium spp.
● Colony initially velvety & white becoming powdery and blue green with a white periphery
● Flask shaped phialides with chains of round phialoconidia
● May cause mycotic keratitis, penicillosis, otomycosis, onychomycosis and rarely deep infections
Scopulariopsis spp.
● Single unbranching or penicillus like annellophores
● Flask shaped annellides
● Lemon shaped annelloconidia in chains (conidia become echinulate with age)
● May cause mycotic keratitis, rarely bronchopulmonary disease, otomycosis, and onychomycosis
Sepedonium spp.
● Colony is initially waxy white and later becomes velvety and lemon colored
● Large round smooth to rough macroconidia which form at the ends of simple or branched conidiophores
● Conidiophores not well differentiated from the mycelium
● Not known to be a human pathogen
HUMAN INFECTIONS CAUSED BY SAPROPHYTES
● Infections most often seen in immunocompromised hosts
ASPERGILLOSIS
● Acquired by inhalation of the conidia
● Usually begins as a pulmonary disease with granulomatous lesions in lungs or bronchi
● Brain, G.I. Tract, and Kidneys may also be involved
● Disseminated disease is usually acute and fatal
● Asthma attacks can be initiated in sensitized individuals by inhaling the conidia
● Aspergillus fumigatus is most commonly isolated from invasive pulmonary aspergillosis, fungus ball, and allergic pulmonary disease
● Direct mounts of specimens reveal septate hyphae that branch dichotomously (Y shaped branching)
MYCOTIC KERATITIS
● With predisposing factors, fungi can invade the cornea
● Such factors include; trauma to the eye, use of corticosteroids, and glaucoma (Contact Lens wearers)
● A white or cream colored infiltrate develops after conidia germinate
● Hyphal growth forms in the area of trauma
● Ulceration occurs in the cornea, eventually causing scarring and blindness
● Lesions may elicit an inflammatory response
● Corneal scrapings are taken for direct mounts and culture
● Majority of cases caused by Fusarium solani
OTOMYCOSIS
● A fungal infection of the external auditory opening or ear canal
● Symptoms include inflammation, itching, scaling
● Partial deafness may occur due to the ear canal being filled with a hyphal plug
● Too much heat and moisture predispose to infection
PENICILLIOSIS
● Acquired by inhalation of the conidia of Penicillium, Scopulariopsis, or Paecilomyces.
● Begins as a pulmonary disease and may disseminate to the rest of the body (CSF, Kidneys, endocardium)
● Such total invasion occurs in debilitated patients
● May also include nail infections (Scopulariopsis), otomycosis (Penicillium), mycotic keratitis (Penicillium, Scopulariopsis), as allergic bronchial asthma in sensitized individuals
● Diagnosis depends on repeatedly isolating the organism in large numbers
ZYGOMYCOSIS
- acute fungal infx 2/2 members of the Zygomycetes
- commonly grow on bread and fruit
- Airborne spores are inhaled and may infect the nasal sinuses and orbital area (eye)
● Predisposing factors: patients with acidosis as in diabetes or malnutrition, also corticosteroids, antibiotics, antileukemic drugs
● Infection may spread to brain and meninges, lungs, G.I. Tract,
● Death ensues 2-10 days after initial sinus/eye infection
● A chronic self-limiting form of zygomycosis has been observed in subcutaneous lesions
● Direct mounts of specimens show large, broad, branching aseptate hyphae. (round sporangia may also be present)
● Causative agents include Rhizopus, Mucor, Absidia, Rhizomucor, Apophysomyces, Saksenaea
Penicillium marneffei
● A pathogenic dimorphic fungus endemic to S.E. Asia
● Infects immunosuppressed (AIDS patients) as well as immunocompetent individuals
● Associated with the bamboo rat
● Causes a focal cutaneous or mucocutaneous infection as well as a progressive disseminated form that is often fatal
● Granulomatous, suppurative, and necrotizing inflammatory response
● At 25 C: grows rapidly & produces blue-green to yellowish colonies with a brown-red reverse (soluble red pigment diffuses into the agar)
● At 35 C: oval yeast-like cells with septate, abortive, extensively branched or highly septate hyphae
● Yeast-like organisms 2-6μm on direct exam
● Specimens include; blood, bone marrow, skin, lung tissue, lymph nodes, urine, stool, CSF, internal organs, etc.
Synecephalastrum racemosum
Ubiquitous, esp in soil / decaying plants, rarely causes systemic or nail infx
- Gray-white colonies, 45 degree branching, no phialides, rare septae
-- can look like Aspergillus or Fusarium, but less septae
- tx not well researched, but possibly AmphoB
Lichtheimia corymbifera



Mucor does NOT have a rhizoid
Mucor spp
Rhizopus has rhizoids at the FOOT of the sporangiophore


Rhizopus
Alternaria

Aureobasidium


Cladosporidium
Curvularia


Bipolaris

Epicoccum

Nigrospora



Paecilomyces

Gliocladium

Fusarium

Chrysosporium

Sepedonium

Scopulariopsis

Penicillum

Absidia has rhizoids, but they NEVER occur at the base of the sporangiophore
Aspergillosis

Zygomycosis

P marneffei - yeast cells c prominent central septum

P marneffei - microscopic mold form

Systemic Mycoses
●Only four organisms classically cause the systemic mycoses which also cause cutaneous infections w/o systemic involvement
●Direct mounts are important: Preliminary diagnosis can be based on observing the tissue phase
●All four are Dimorphic, all except C. immitis are Thermally Dimorphic
●Serologic procedures important in establishing dx
●Conversion to tissue phase important in id
●Safety a prime consideration working c these fungi
●Treatment for all four fungi is normally Amphoteracin B
A. Coccidioides immitis --> Coccidioidomycosis
B. Histoplasma capsulatum --> Histoplasmosis
C. Blastomyces dermatitidis --> Blastomycosis
D. Paracoccidioides brasiliensis --> Paracoccidioidomycosis
COCCIDIOIDOMYCOSIS
●Coccidioides immitis the etiologic agent
●Soil, endemic in SW U.S. including California
●Arthroconidia found in the soil
●Dry dusty winds stir up the arthroconidia-bearing soil
●Human infx after inhalation of arthroconidia
Arthroconidia (arthrospores) Enter the lungs and round up in four to five hours
● Enlarge and develop a thick wall in four to five days
● Form spherule containing up to 800 endospores
● Most specimens respiratory secretions
● Sputum, transtrachael aspirates, etc.
● In disseminated dz, may submit any specimen
● Biopsy material, skin, CSF, etc.
Sx: 6/10 exposed get asx resp infx after 10-14 days
● Other 4/10 get mild or rarely severe influenzalike dz called Primary Pulmonary Coccidioidomycosis
● Most patients recover
● If immune response is compromised, patients may succumb to a gradual or rapid disseminated disease (<1% of all infected )
● Px good in Primary Pulmonary Coccidioidomycosis
● Px poor in disseminated cases (may be fatal)
Dx: Normally look for mixture of immature and mature spherules containing endospores
● Spherules are the tissue phase
● Histology stains helpful (H&E, PAS, GMS)
CULTURE: All work must be done in a safety cabinet
● Inoculated media include SAB, Mycosel, SABHI, Smith's Fungal Medium, BAP
● Grows as a mold at both 25○C and at 35○C
● Observe hyphae and arthroconidia
● Arthroconidia are barrel shaped and separated by alternating disjunctor cells
● Moist white colony forms which later becomes covered with a white fluffy mycelium
● 90○ branching of hyphae can be observed
● Exoantigen test for definitive identification
● Converse medium can be used to demonstrate spherules
SEROLOGY: Coccidioidin and Spherulin used for skin tests
● CF antibodies; Diagnostic and prognostic
● Precipitin test also available
Ddx: Rhinosporidium seeberi (spherules 100-300uM and Mucicarmine + endospores)


Coccidioides immitis


C immitis spherule in lung


mold form





Disseminated histo

HISTOPLASMOSIS
● Histoplasma capsulatum the etiologic agent
● Widely distributed in soil, esp Mississippi valley
● esp in soil enriched with bird and bat feces
● Orgs multiply in bird droppings and are inhaled
● Chicken coops, bat guano, starlings
Sx: subclinical self-limited respiratory infection occurs
● small % develop chronic cavitary pulmonary
dz with productive cough & X-ray resembling TB, may see coin lesion on CXR
● pulmonary illness can become severe and spreads
hematogenously to the spleen, liver, adrenals, kidneys, skin, and CSF
● untreated, disseminated form is often fatal
● Infection of the reticuloendothelial system
SPECIMENS: Sputum is not a good specimen
- BM, lung biopsy, blood smears from AIDS patients
- Dx made by finding antigens in serum, urine or CSF
DIRECT EXAM: Organisms rarely seen in sputum
● Observe small yeast within macrophages (no capsule but may have a small halo; vs Leishmania)
● Giemsa, Wright's Stain
CULTURE: SAB and Mycosel at 25C
● SABHI and BHI at 35○C
● Slow growing colony initially moist, later developing a low white to brown aerial mycelium
● Mature colonies may be glabrous, velvety, or woolly
● Tease mounts: conidiophores at 90○ to hyphae
● Observe large round macroconidia with smooth, spiny, or finlike edges (tuberculate macroconidia)
● Microconidia are small round to teardrop shaped, smooth or rough, along sides of hyphae
● Yeast phase (35○C) shows small, single-budding yeast cells
● Histoplasma capsulatum is a Dimorphic fungus
● Exoantigen test is available
SEROLOGY: Histoplasmin can be used for skin test but many cross reactions are observed
- macroconidia look like those of Sepedonium spp (a non-microconidia-producing moderately fast-growing saprophyte that doesn't grow at 37C [H capsulatum is slow growing])


BLASTOMYCOSIS
Blastomyces dermatitidis the etiologic agent
● Ohio river valley & other midwest river valleys
● fungal conidia are inhaled
● attempts to isolate from soil usually fail
SPECIMENS: Sputum often submitted in primary respiratory dz; Pus from lesions, also urine and CSF
Sx: Blastomycosis divided into pulmonary, cutaneous, and systemic forms
● All forms of disease originate from Primary Pulmonary Blastomycosis
● Respiratory disease is similar to Tuberculosis
● Without tx, infx disseminates to rest of the body
beginning at adjacent subcutaneous tissues
● Skin and bone lesions assoc c systemic spread
● Skin lesions are very suppurative, ulcerated, crusty, weepy, with small abcesses in the center
● Oral and nasal mucosa may be involved
● Bone lesions painful, result in loss of function
● Prognosis is poor without therapy
● Also referred to a Gilchrist's Disease or North American Blastomycosis
DIRECT EXAM : KOH Prep: single budding, thick walled yeast with broad base of attachment (Isthmus) *** Broad Based Buds ***
CULTURE: SAB, Mycosel, at 25○C
- SABHI, BHI, at 35○C
- Blastomyces dermatitidis is a Dimorphic fungus
● Mycelial phase: Single small smooth walled round to oval conidia at the ends of short conidiophores or directly on the hyphae
● Yeast cultures: Uniformly spherical blastoconidia with thick refractile walls
● A single bud is characteristically attached to the mother cell by a wide septum which is diagnostic
● Exoantigen test is available
SEROLOGY
● No specific serologic skin test
● CF test is available

Yeast (lt) and Mold colony (rt)

Yeast form in tissue

Mold colony
PARACOCCIDIOIDOMYCOSIS
● Paracoccidioides brasiliensis the etiologic agent
● Primarily seen in South America especially Brazil
● Oral mucosa and gums become infected from trauma caused by chewing contaminated vegtable matter or using fungus infected twigs as toothpicks
● Actual source unknown, perhaps soil & vegetation
● referred to as South American Blastomycosis
Sx: Crusted ulcers may spread to the tonsils, nasal
mucosa, and face
● Organisms from oral infection or air inhaled, producing pulmonary lesions similar to tuberculosis
● Fungi from the oral ulcers or contaminated food are swallowed and cause intestinal manifestations (may spread to liver & spleen)
● Lymphatic enlargement most notable clinical sign
● Patient usually expires in 2 to 3 yrs. from disseminated disease and/or inability to eat
● Women are remarkably resistant to infection
SPECIMENS: Specimens come from whatever area of the body is affected
DIRECT EXAM: KOH Prep: multiple budding yeast with a narrow zone of attachment
● Ship's Wheel, Pilot's Wheel, etc.
CULTURE: SDA, Mycosel, at 25○C
● SABHI, BHI, at 35○C
● Paracoccidioides brasiliensis Dimorphic fungus
● Mold: very slow growing, observe few tiny microconidia, hyphae with intercalary & terminal chlamydoconidia
● Yeast: multiple budding yeast with narrow zone of attachment
SEROLOGY
● Paracoccidioidin can be used to evaluate incidence of infection
● CF, FA, and immunodiffusion test have been described


Yeast at 37C (lt), Mold at RT (rt)
Multiple budding yeasts cells of Paracoccidiodes

Superficial and Dermatophytic Fungi
Superficial mycoses are noninvasive and basically asymptomatic, involving only the top keratin containing layers of skin & hair
Cutaneous mycoses affect the deeper epidermal layers, producing more tissue destruction and symptoms
- Diagnosis is normally by direct exam (KOH prep of hair, nails, skin)
TINEA (RINGWORM)
● Tinea corporis: body - Tinea unguim: nails
● Tinea cruris: groin - Tinea pedis: feet
● Tinea capitis: scalp - Tinea manum: hands
● Tinea barbae: beard
SUPERFICIAL ORGANISMS
HORTAEA WERNECKII (PHAEOANNELLOMYCES WERNECKII)
● Black yeasty, tar-like colony which later becomes covered with short olive grey mycelium
● Yeast portion contains only dark 1-2 celled blastoconidia
● Mold portion: hyphae develop with dark 1-2 celled blastoconidia in large clusters along the hyphae
● Causative agent of Tinea nigra
MALASSEZIA FURFUR
Dx cobserving KOH preps of skin scrappings
- Thick round to oval cells in clusters and short angular hyphae ("spagetti and meat balls")
- Will not grow on routine culture media unless olive oil is added
● Causative agent of Tinea versicolor (Pityriasis versicolor)
- may cause folliculitis in BMT and neutropenic pts
- Disseminated infection sometimes seen in infants and young children receiving lipid replacement therapy
EM: characteristic feature are thick multilayer budding, unipolar budding, broad-based buds, collarette and corrugations or foldings of cell wall
PIEDRAIA HORTAE
● Causative agent of black piedra which consists of firmly attached hard black nodules on scalp hair
● Compact greenish black colony. Heaped and glaborous
● Dark thick-walled hyphae with swellings
● Asci containing ascospores may be present on direct exam (KOH)
TRICHOSPORON BEIGELII
● Causative agent of white piedra which consists of light brown to yellow soft nodules around beard and mustache hairs
● Hyaline hyphae with blastoconidia and arthroconidia
● White to cream colored wrinkled glaborous yeast like colony
● Look for arthrospores on direct exam
DERMATOPHYTES
GENERAL DIFFERENTIAL CHARACTERISTICS
Location of the ringworm (tinea)
● Dermatophytes infect specific body sites
● Ringworm location may aid in preliminary identification
- Microsporum infects skin, nails, and hair
- Epidermophyton infects skin and nails
-Trichophyton mentagrophytes, T. rubrum, and T. verrucosum infects skin, nails, and ectothrix hair
- Trichophyton tonsurans, T. schoenleinii, and T. violaceum infects skin, nails, and endothrix hair
Hair fluorescence
● Fluorescence in observed with Microsporum
● Pteridine produces a bright greenish yellow fluorescence when observed under a Wood's Lamp
● Fluorescence is helpful in selecting infected hairs from uninfected hairs
● Fluorescence is observed with Microsporum canis, M. audouinii, M. distortum, and M. ferrugineum
Growth Rate
● All Microsporum spp. except M. audouinii are intermediate growers forming mature colonies in 6-10 days
● All Trichophyton spp. except T. mentagrophytes are slow growers forming mature colonies in 11-21 days
● Epidermophyton floccosum is an intermediate grower
Microscopic characteristics
● Most important criteria for genus identification
● Characteristics may be rapidly lost with subsequent transfers
● Conidia formation enhanced by subculturing to media low in nutrients ( ie. PDA)
Microsporum spp.
● Produce numerous rough thick or thin walled elliptical or spindle shaped macroconidia with 3-7 cells
● Rare club shaped MACRO-conidia borne singly along the hyphae
● M. audouinii is an exception and rarely produces either macroconidia or microconidia
Epidermophyton floccosum
- Produces numerous smooth thin walled club shaped (or beaver-tailed) macroconidia with 2-4 cells
- no microconidia; only spp in the genus
Trichophyton spp.
● Usually form rare thin walled pencil shaped MICRO-conidia with 3-8 cells
● Some strains produce numerous macroconidia
● T.schoenleinii and T. violaceum do not produce macroconidia under normal conditions
Physiologic characteristics
- Urease test, carbohydrate assimilations, utilization of various nitrogen containing compounds can be used to differentiate the three genera
● Nutritional procedures using vitamin requirements are often used to differentiate Trichophyton spp.
- specialized Trichophyton agars are available
DERMATOPHYTES PATHOGENIC TO MAN
Microsporum spp.
a) Microsporum audouinii
● Causative agent of tinea corporis and childhood epidemics of tinea capitis
● Ectothrix infected hairs fluoresce yellow green
● Does not grow on rice medium
● Anthropophilic (seen primarily in man)
● Rare irregularly shaped macroconidia with thick rough walls and 2-9 cells
● Rare club shaped microconidia, singly along the hyphae
● Raquet hyphae, nodular bodies, terminal vesicles
b) Microsporum canis
● Zoophilic (seen primarily in cats and dogs)
● Causes tinea corporis and tinea capitis
● Ectothrix infected hair fluoresces yellow green
● Reverse of colony is bright yellow to yellow orange
● Grows on rice medium
● Numerous macroconidia; rough, thick walled, spindle shaped with 6-15 cells
● Few one celled club shaped microconidia
c) Microsporum gypseum
● Causes an inflammatory tinea corporis and tinea capitis
● Geophilic fungus (lives in soil and dirt)
● Ectothrix infected hair does not fluoresce
● Numerous macroconidia; rough, thin walled elliptical shaped with 4-6 cells
● Few single celled club shaped microconidia
Epidermophyton floccosum
● Causes epidemic tinea pedis in summer camps & institutions also tinea cruris and tinea unguium
● Velvety khaki yellow colony with a tan reverse
● Numerous club shaped smooth thin walled macroconidia with 2-4 cells
● Macroconidia are borne singly or in clusters
● No microconidia develop
Trichophyton spp.
a) Ectothrix Hair Invasion
1) Trichophyton mentagrophytes
● Causes an inflammatory tinea pedis as well as tinea corporis, tinea unguium, tinea barbae, and tinea capitis
● MCC athletes foot
● Colonies can be either floccose or granular
● Fluffy colonies are usually white with yellow reverse
● Granular colonies usually buff with pigmented reverse
● Fluffy colonies rarely demonstrate macroconidia
● Granular colonies: numerous pencil shaped smooth thin walled macroconidia with 5-8 cells
● Round microconidia in grape like clusters
● Hair perforation test is positive
2) Trichophyton rubrum
● Causes tinea corporis, tinea pedis, tinea cruris, and tinea unguium
● Granular or fluffy white colony with pink periphery and a deep red reverse
● Smooth walled pencil shaped macroconidia with 3-8 cells
● Numerous club shaped microconidia borne singly along the hyphae
● Hair perforation test is negative
3) Trichophyton verrucosum
● Causative agent of tinea capitis, tinea barbae, and tinea corporis
● Usually acquired from cattle
● Requires thiamine for growth
● On ordinary SabDex agar only chlamydoconidia in chains
● On thiamine enriched media rare 3-5 celled macroconidia with an elongated rat tail end are observed
● Moderate numbers of club shaped microconidia along hyphae
b) Endothrix Hair Invasion
1) Trichophyton schoenleinii
● Causes tinea capitis and rarely tinea corporis & tinea unguium
● Causes a favus hair type of endothrix hair invasion
● No macroconidia are formed under routine conditions
● Favic chandeliers are most prevalent microscopic feature
● Microconidia are formed on rice grain media
2) Trichophyton tonsurans
● Causes black dot type of tinea capitis
● Occasionally causes tinea corporis, tinea pedis, and tinea unguium
● Three colony types may be observed
● Rare club shaped smooth walled macroconidia
● Numerous microconidia with great variation in size & shape
● Hair perforation test is negative
● Growth is better in presence of thiamine
3) Trichophyton violaceum
● Causes tinea capitis and tinea corporis
● Can rarely cause tinea unguium and deep infections
● Waxy or suede violet heaped colony with lavender reverse
● Grows best on SabDex with trypticase and thiamine
● Usually only chlamydoconidia in chains and hyphal swellings are observed
● Few microconidia may be formed on thiamine enriched media
Ringworm of the face


Tinea pedis
Tinea nigra



Malassezia furfur

Black piedra

White piedra
Hair fluorescence

Spindle-shaped macroconidia

Trichophyton

Epidermophyton floccosum

Microsporum audouinii causing tinea capitis

Macroconidia of M audouinii

Microsporum canis


Positive hair perforation test in Trichophyton mentagrophytes
Trichophyton rubrum

Trichophyton verrucosum

T schoenleinii favus hair type of endothrix hair invasion

T tonsurans black dot ringworm

Subcutaneous Mycoses
● limited to skin and subcutaneous tissues
● traumatic implantation into skin
● spreads slowly along the lymphatics in some
● caused by saprobes that exist in soil, on plants, and in decomposing vegetation
● Poor nutrition may play a role is susceptibility to infection
● Most commonly found in subtropical and tropical areas of the world
● Typical patient works outdoors, w/o shoes, and wears shorts
SPOROTHRIX SCHENCKII (SPOROTRICHOSIS)
- now known as Mesomyecetozoans (fish parasites)
DIMORPHIC fungus; caused by innoculation by penetrating injury c thorn (rose-gardener's dz)
- yeast at 37C (HEAT YEAST) and IN VIVO (tissue phase)
- yeast forms (Cigar Bodies) grows as a mold at 25C (COLD MOLD),
- has clusters of oval conidia at the tip of long
Sx: 5 clinical types of infection, lymphocutaneous MC
● Primary lesion develops as pustule, abcess, or ulcer that then involve local lymphatics
● Multiple subcutaneous nodules occur along lymphatics
● Infection can also be acquired through inhalation resulting in pulmonary sporotrichosis
conidiophores (resembling a daisy or daisywheel)
Dx: Direct Exam - organism rarely seen in pus or tissue
Immuno- Host response primarily CMI, little Ab response
● Skin test available (sporotrichin)
+ test = infection at some time
- test = absence of infection
● Latex agglutination and tube agglutination tests are also available
Epidemiology:
● Occurs worldwide, occupational hazard
● Source: soil, wood, thorns, plants
● Epidemics rare, sporatic cases more common
● Outbreaks in gold mining workers in South Africa
Treatment:
● Potassium Iodide administered orally
● Amphoteracin B is drug of choice for disseminated, recurrent, or pulmonary forms
MYCETOMA
Sx; Chronic granulomatous infection involving the lower extremities (aka Madura foot)
● Localized swollen draining lesions with granules
● Lesions in cutaneous, subcutaneous tissue, facia, and bone
● Draining sinus tracts discharge pus that contains granules
● Untreated lesions extend through muscle and into bone
- MUST id the causative agent
● About one half of cases caused by fungi
● Other cases are caused by members of the Actinomycetes
Eumycotic Mycetoma
- 2% of cases; usually black molds; Local
● Treatment difficult
- Many species of fungi; MCC are Pseudoallescheria boydii, Madurella spp, Pyrenocheta, Leptospira, Curvularia, Exophiala jeanselmei, Neotestudina
- Painless lesions
- in the granules: true hyphae vs bacterial filaments
Actinomycotic Mycetoma
- 98% of cases; members of the actinomycetales which are higher bacteria (MCC are Nocardia brasilienses, N asteroides, Actinomyces israelii;
-- when Actinomyeces causes lesion may see Splendore-Hoeppli phenomenon and sulfure granules
- Nocardia may cause positive (red snapper) on acid0fast
- Painful bone lesions, More aggressive
- Effective treatment
● Diagnosis of mycetoma should never be made unless granules are seen
● Granules are composed of microcolonies of the fungus and a proteinaceous material from the host
● Granules: note color, size, shape, texture
● Fungal agents include species of Madurella, Aspergillus, Pseudoallescheria, Acremonium, and Leptosphaeria
● Pseudoallescheria boydii most common in U.S.
Tx:
● Actinomycotic Mycetoma - sulfonamides and sulfones
● Fungal Mycetoma - no established therapy, surgery to remove swollen tissue, then administration of ketoconazole (effective therapy requires 9-12 mo)
● Chronic infection may ultimately require amputation of the affected limb
CHROMOBLASTOMYCOSIS OR CHROMOMYCOSIS
Sx; Slowly progressive granulomatous infx of skin
● Lesions develop from scaly papules on skin to warty-like lumpy lesions containing black dots
● eventually become "cauliflower-like" nodules
● Elephantiasis may result from obstruction and fibrosis of lymph channels
● Lesions itch but are basically painless unless accompanied by secondary bacterial infections
● No bone involvement
Dx: Direct Exam: KOH prep from skin (has hyphae)
● Pus or tissue may contain Sclerotic Bodies which are diagnostic (copper penniesm Medlar bodies)
● All agents appear identical in tissue
● Fungal agents include: Fonsecaea pedrosoi, Fonsecaea compacta, Phialophora verrucosa, Cladosporium carrionii, and Rhinocladiella aquaspersa
● All agents of Chromomycosis are dematiaceous
● Culture: look for characteristic conidia and arrangement
● Cl. carrionii - branching chains of conidia on long conidiophores
● Ph. verrucosa - flask shaped phialides, collarettes
● Rhinocladiella aquaspersa - conidia produced sympodially
● F. pedrosoi - sympodial, phialides, or cladosporium sporulation may all be observed
Epidemiology
● Disease occurs mainly in the tropics but is seen world wide
● Certain species predominate in specific geographical areas
● M>F
● Fungi are found in soil and on vegetation
Tx
● Flucytosine and Thiabendazole given orally
● Surgical removal of infected tissue
PHAEOHYPHOMYCOSIS
- collection of a wide variety of clinical diseases caused by a large number of dematiaceous fungi.
- is a saprophyte found in soil, plants, nature
Sx Currently, phaeohyphomycosis is limited to the subcutaneous and systemic infections caused by the dark-walled hyphae usually in the tissue
● In tissue: dark yeast-like cells, pseudohyphae-like elements, hyphae, or a combination of all these
● Sclerotic bodies and granules are not seen
● Infections are seen primarily in immunocompromised individuals
Dx: Direct exam: Place in 10% KOH, heat gently, apply coverslip, and observe for presence of dark brown hyphae (from melanin-like pigment)
● Specimens include aspirates, surgical specimens, biopsies, scrapings, curettage of plaques & nodules
● Many of the fungi are saprophytes that do not cause disease in normal hosts and include; Alternaria, Aureobasidium, Bipolaris, Cladosporium,
Curvularia, Dactylaria, Phaeoannellomyces, Exserohilum, Fonsecaea, Phialophora, Scedosporium, and many others
● Identification is accomplished using standard mycological techniques
● Selective & non-selective fungal media is employed and incubated at
30○C and 37○C and held for 4wks or longer before discarding
● Slide cultures should be made for specific id
Epidemiology
● Most of the etiological agents are found in soil and on decaying plant material
● Some are plant pathogens
● May also be recovered as contaminants from clinical specimens
● Phaeohyphomycosis occurs world-wide in immunocompromised hosts
Treatment
● Treatment will vary somewhat depending on the agent isolated and the site and extent of infection
● The immunological state of the host is a primary consideration
HYALOHYPHOMYCOSIS
Saprophytes (free-living) in soil, plants, nature
- Mycotic infx caused by hyaline hyphomycetes, tissue morphology is mycelial (vs phaeohyphomycosis which is brown)
- unusual hyaline fungal pathogen
- Hyaline, hyphae that are well septated (many
cross-walls), branch at approx. 45° angles
("bifurcations‟)
• Aspergillus is the prototype. Culture necessary
for speciation (Many others: Penicillium, Fusarium,
Paecilomyces, Scopulariopsis, Trichosporon,
Geotrichum, Acremonium, Trichoderma, Gliocladium, Sepedonium, Beauveria, Chrysosporium, etc.)
Sx: Vasoinvasive, thrombosis, infarctions
• Suppurative inflammation, coagulative necrosis
• A word of caution: NO sure WAY to differentiate aspergillosis on histology alone from other hyalo- and some phaeohyphomycetes, unless an air-containing space is involved in vivo, is represented in the sampled tissue, and fruiting bodies are seen in
tissue (not very common)
Micro: “Flask-shaped vesicles present, with early rows of conidia c/w Aspergillus spp. Await culture
confirmation for definitive identification.”
• If NO pathognomonic fruiting bodies present in tissue, and only regular-sized, septated hyphae with bifurcations are present, your safest call in tissue is: "septated hyphae are present c/w a filamentous mold, await culture confirmation for definitive identification‟
- H&E slide: fruiting body formation in tissues, rare phenomenon, (usually lungs), implies access to air-containing space, as in emphysematous cavity, evacuated tumor center, etc
LOBOMYCOSIS
Synonyms: Keloidal blastomycosis or Lobo's dz
- Rare chronic cutaneous and subQ infection 2/2
Lacazia loboi previously called Loboa loboi
Sx: Keloids, verrucoid to nodular lesions, crusty
plaques, and tumors
- Fungus grows as globose cells connected to each
other by a narrow neck; may form branching chains
- Developing lesions well defined, smooth, painless
- Older lesions typically verrucoid and ulcerative
with satellite lesions resulting from autoinoculation
Micro: Subepidermal histiocytic granulomas, minimal
fibrosis with large numbers of giant cells and histiocytes
- In older lesions: pyogenic infiltrates and acanthosis
- Chains of globose cells 7-14 μm (average 10 μm) connected by a narrow neck, sequential budding may produce chains of up to 6 to 10 yeasts
- Yeasts may lie within giant cells and macrophages; asteroid bodies are common
- Isolation in culture: has never been achieved,
except in mice foot pads
• Natural habitat: Unknown, but the infection is also found in dolphins

Sporotrichosis
Lymphangitic arm


Sprothrix Cigar Bodies in yeast form

Sporothrix daisy head mold form

mycetoma

Conidia nd conidiophores of Scedosporum apiospermum
Cleistothecia and ascocarps of Pseudallescheria boydii


Chromoblastomycosis


sclerotic bodies diagnostic

Different sporulation patterns
Phaehyphomycosis


Subq phaeomyphomycosis caused by Exophiala jeanselmei

Cladosporium (lt) and philophora (rt), olive-blk colors

Hyalohyphomycosis

Hyalohyphomycosis

Yeasts
References
1. Notes from the U
2. Godd pics: Dr Fungus
● Unicellular, round to oval blastospores, 2.5-6μm diameter
● Reproduce by budding
● Blastoconidia, true hyphae, pseudohyphae, germ tubes, arthroconidia, chlamydoconidia
● Colonies are moist, creamy, or membranous
● Most yeast infections are acquired endogenously
● Yeasts are the most common fungi isolated in the clinical laboratory
DIRECT MICROSCOPIC
● Gram stain, KOH prep, India Ink
● Budding yeast cells and pseudohyphae = invasive (tissue phase)
● Yeast cells only - saprophyte ?
IDENTIFICATION OF YEASTS
● Gram stain, wet mount, LPCB to confirm as yeast
● Germ tube, sucrose assimilation, urease
● Corn meal agar for morphology (pseudohyphae, true hyphae, blastoconidia, chlamydospores, etc.)
● Growth at 35C and 42C, Pellicle formation in broth, India Ink, assimilation & fermentation tests, KNO3 assimilation, ascospore production, Birdseed agar,
Cyclohexamide resistence
CANDIDIASIS
Infection by a member of the genus Candida
- usual flora of both GI and mucocutaneous areas
- Candida albicans MC in human infections
Sx: a) Mucocutaneous involvement: thrush, glossitis, stomatitis, cheilitis, vaginitis, balanitis, bronchial, pulmonary, alimentary, and chronic mucocutaneous candidiasis
b) Cutaneous: intertriginous, generalized canididiasis, paronychia, onchomycosis, diaper disease, granuloma
c) Systemic: urinary tract, endocarditis, meningitis, septicemia
d) Allergic: candidid, eczema, asthma, gastritis
Morphology and ID
a) Direct Exam: budding yeast only or with pseudohyphae (is triphasic c yeasts, pseudohyphae and hyphae)
b) Culture: many species of Candida, numerous biochemical test available for identification
Candida albicans : Germ tube positive (grow yeast in serum in 2h), sucrose assimilated, chlamydospores made, pseudohyphae, blastoconidia, urease negative.
- white, dull, spider-like colony on bacteriologic media
Tx varies widely with infx site + extent of involvement
● Ketoconazole, amphoteracin B, flucytosine, nystatin, miconazole plus various chemicals
CRYPTOCOCCOSIS
Cryptococcus neoformans is etiologic agent
● yeast with a large carbohydrate capsule
● widely in nature, particularly in dried pigeon poo
Sx
● Most infx in immunocomromised (AIDS patients)
● Infection occurs via the respiratory tract
● Slowly developing chronic meningitis
● Disseminated dz may occur w/wo meningitis
● Skin lesions may occur which may ulcerate
● Less common; endocarditis, hepatitis, renal infx
Morphology and ID
a) Direct Exam: India Ink Prep. to observe budding yeast cells with a wide capsule (may vary in size)
b) Culture: Mucoid yeast colony at both 25○C and 37C observe yeast with single bud and wide capsule
● Urea positive, assimilates carbohydrates but does not ferment
● Brown pigment on Birdseed Agar
- Cryptococcal Antigen Latex Agglutination Test very sensitive, can be done on CSF, plasma, urine
Tx: Flucytosine and Amphoteracin B
Cryptococcus gattii
- Previously only in tropical and subtropical regions
- More recent cases in Vancouver and the Pacific nw, assoc c Eucalyptus trees
- Affects both animals and humans
- Globally, about 1,000,000 cases/yr. >600k deaths
- Airborne spores easily inhaled, no P2P spread
- Specific subtypes assoc c increased virulence
- Mortality rate ≈ 25%
Sx: Infections in immunocompetent individuals
-Incubation period from two to six months or longer
- lingering cough, sharp chest pain, shortness of breath, headache, fever, nighttime sweats, weight loss, meningitis, etc.
Morphology and Lab ID
- Morphologically and biochemically identical to Cr. Neoformans
- Positive tests; Urease and melanin production on birdseed agar
- Growth and blue color on CGB (Canavanine-Glycine-Bromothymol Blue) yellow agar
- Capsules present
Tx: Early dx and tx c Amphoteracin B
- No vaccine available
OTHER YEAST SPECIES
1. Other Candida spp.
● C. tropicalis, C. parapsilosis, C. guilliermondii, plus many others
● C. stellatoidea is Germ tube + but sucrose neg
● C. krusei is considered innately resistant to fluconazole and must be r/o for antifungal to be used
● C. glabrata causes infections in the bloodstream or urogenital tract as well as the lung and other sites
● C. glabrata has shown emerging resistance to amphoteracin B and fluconazole
Geotrichum candidum
● Usual flora in humans but most commonly causes bronchial infection in severely compromised hosts: chronic cough, mucoid bloody sputum
● Oral infection resembles oral candidiasis
● Intestinal dz results in colitis and bloody stools
● Dry mealy white colonies on SabDex
● Coarse, true hyphae that segment into rectangular arthroconidia
Trichosporon spp.
● Increasingly involved in invasive localized and disseminated disease esp in immunocompromised
● Recent taxonomic revisions have resulted in numerous distinct species but only five of these are clinically significant
● Clinically significant species include; T. asahii, T. mucoides, T. cutaneum, T. inkin, and T. ovoides
● Membranous white wrinkled colonies on SabDex
● True hyphae, arthroconidia, blastoconidia
● Urease positive
Rhodotorula spp.
● Often present in terminal stages of debilitating dz
● Blastoconidia only, maybe capsule, urease +
● Pigments: Pink, coral, red, orange
Saccharomyces cervesiae
● Generally considered nonpathogenic
● Blastoconidia, yeast with ascospores
Blastoschizomyces capitatus
- aka Geotrichum capitatum / Trichosporon capitatum
- Invasive systemic infx in immunocompromised hosts
especially neutropenic leukemia patients
- Recent increase in central Europe
YEASTLIKE ORGANISMS
Prototheca spp.
● Colorless (achlorophyllous) algae whose growth appears yeast-like
● protothecosis: Prototheca wickerhamii & Pr. Zopfii
● infx skin and subcutaneous tissue, rarely systemic
● Bursitis of elbow typically exhibits necrotizing granulomas
● Round / oval sporangia c 2-20 endospores
Pneumocystosis
Etiologic agent - Pneumocystis jirovecii , formerly Pneumocystis carinii, once considered a parasite
- Many similarities with Saccharomyces cervisiae
- Human tissue is one reservoir for P. carinii . The fungus may be acquired in infancy and remain dormant in tissues until some weakness of the individuals immune system provides an opportunity for infection
- P. carinii pneumonia (PCP) often 1st opportunistic infx in HIV positive individuals, c diffuse interstitial plasma cell pneumonia that resembles Mycoplasma pneumoniae
- multiplies in alveolar spaces --> distented alveoli from secretions. infx usually stays localized in lung
- The organism does not grow on routine culture and dx usually made using immuno-specific stains
- cysts nonbudding, round ovoid, or collapsed crescent forms c thickenining in wall, appear as single or double Acommas@ or a set of parentheses
● small clusters on thick foamy background
- may be considered a fungus bc there are glucans in cyst wall, has airborne spread, and greater RNA homology with other fungi than parasites
Dx: microscopic id on BAL, induced sputum or tissue bx or smear, seeing cyst wall or trophozoites (intracystic bodies=bradyzoites; extracystic bodies=tachyzoites) c cyst stains (GMS has black dot), organism stains (Giemsa), or immunologic stains (FITC-labelled abs)
Microsporidium - see Parasitology
Rhinosporidiosis
● Rhinosporidium seeberi the etiologic agent
● Infx of mucocutaneous tissue, primarily involving nasal cavity, nasopharynx, and oral cavity
● 2ndary skin infx rarely systemic dissemination
● The organism fails to grow on artificial media
● sporangia (spherules) observed in stained preparations of the infected tissue
● Mature sporangia are thick walled round, large (100-350μm in diameter c lots of sporangiospores
● A zonal pattern of sporangiospore development is uniquely characteristic of this pathogen
● When sporangia rupture and endospores are released, a granulomatous rxn likely but suppurative responses may occur
- Rhinosporidiosis dx'd by direct exam of infxd tissue
Yeast budding
C albicans in urine


Oral Thrush
Severe ulcerative Tinea Pedis
Skin lesion






Producing germ tubes
Chlamydospores
Spider colonies, EMB agar

Protheca

Pneumocystis carinii

Protheca
Rhinosporidiosis, spherule in tissue


Rhinosporidiosis








Rhodotorula
Trichosporon - white piedra infected hair shaft
Geotrichum candidum - gram stain
Candida glabrata
Candida krusei
Candida guilliermondi
Candida parapsilosis
Candida tropicalis
Cryptococcus neoformans skin lesions
Cryptococcus neoformans - brown colonies on Niger seed agar




Cryptococcus neoformans - India ink, csf
